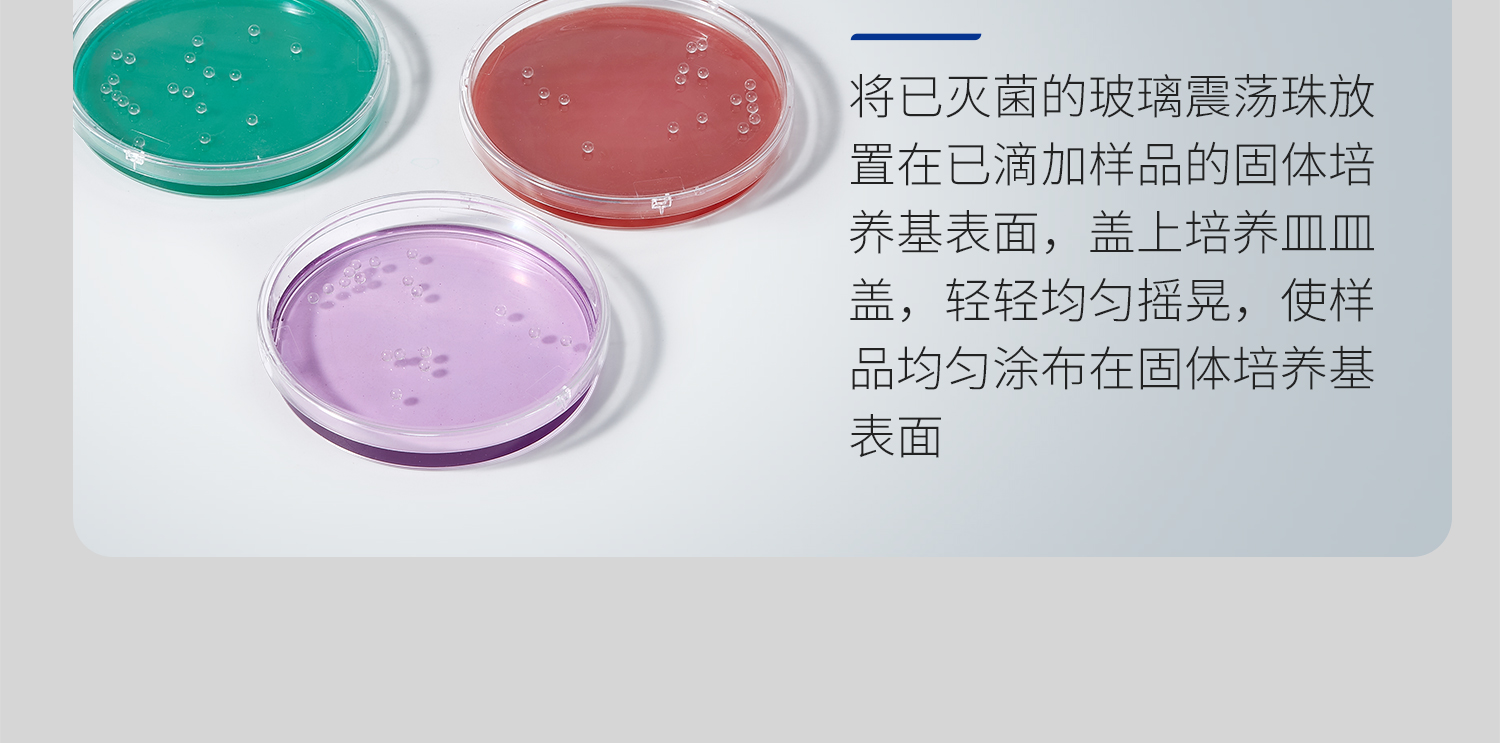
湘玻-玻璃震荡珠详情_16.jpg

中文版
English
加入收藏
玻璃震荡珠
产品名称:玻璃震荡珠
产品品牌:湘玻
产品规格:
-
2.5mm 120606001
-
3mm 120606002
-
4.5mm 120606003
-
4mm 120606004
-
5mm(蓝色) 120606005
-
6mm 120606006
-
7mm 120606007
-
5mm(白色) 120606008